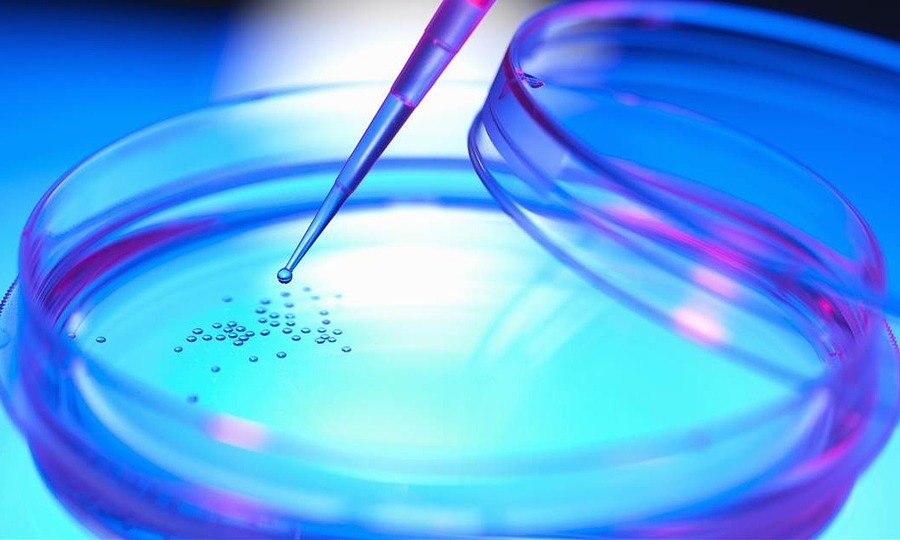

Trước khi nhập viện 2 ngày, bệnh nhân đến thẩm mỹ viện để tiêm tế bào gốc nhằm phục hồi sức sống cho da. Nhân viên thẩm mỹ viện giới thiệu chị là tế bào gốc của Hàn Quốc.
Cách đây vài ngày, bệnh viện Da liễu TP.HCM cũng tiếp nhận một bệnh nhân nữ 40 tuổi, mặt nổi đầy mụn đỏ sau khi tiêm. Tế bào gốc trong suối nước nóng. – Bác sĩ Trần Nguyễn Anh Tú, Phó Giám đốc Khoa Da liễu Thẩm mỹ, Bệnh viện Da liễu TP.HCM, cho biết nguyên nhân dẫn đến biến chứng của những bệnh nhân này là do thành phần của sản phẩm. Tiêm vào da có thể gây ra phản ứng trong cơ thể.
“Ở thẩm mỹ viện tiêm thuốc nóng cho 2 bệnh nhân gọi là tế bào gốc nhưng thực chất trên tường không có tế bào gốc sống. Bác sĩ Tú nói:” Lượm.
Khi sử dụng sản phẩm “tế bào gốc” để tiêm tại chỗ và đường uống, hàng tháng bệnh viện tiếp nhận khoảng 5-7 bệnh nhân bị tác dụng phụ và tai biến, việc điều trị các biến chứng này thường lâu và tốn kém. Nhiều trường hợp không thể chữa khỏi hoàn toàn, để lại biến chứng trên da, bác sĩ Tú cho biết, những năm gần đây rộ lên phương pháp thẩm mỹ cấy tế bào gốc, bác sĩ Quý cho biết: “Hiện tại chưa có cơ sở y tế nào được Bộ Y tế cho phép triển khai Việc ứng dụng công nghệ tế bào gốc trong lĩnh vực da liễu và thẩm mỹ. “Trên thế giới, một số nước đã nghiên cứu tế bào gốc và ứng dụng vào các bệnh da hệ thống và miễn dịch, như vảy nến, xơ cứng bì toàn thân, biểu bì bóng nước hay ung thư da. Trong lĩnh vực lọc máu tinh, tế bào gốc đang được nghiên cứu. Phương pháp điều trị lão hóa da, sẹo và bỏng nặng Trước khi ứng dụng rộng rãi công nghệ này, hiệu quả và độ an toàn của nó đã được nghiên cứu, thực tế trên thị trường có rất nhiều sản phẩm tế bào gốc được bán với giá hàng chục Bác sĩ Tú cho biết, công nghệ chiết tách tế bào gốc đòi hỏi kỹ thuật phức tạp, bao gồm ly tâm, tán huyết hồng cầu và collagen, rửa, phân lớp ma trận … Tế bào gốc đòi hỏi những tiêu chuẩn khắt khe như vô trùng, duy trì ở mức 80 ° C dưới đây.-BS Tú chia sẻ: “Giá sản phẩm tế bào gốc không thể chỉ vài trăm nghìn đồng. “— TS. Tú phân tích, ngay cả những sản phẩm có chứa tế bào gốc khi tiêm vào cơ thể người cũng tiềm ẩn nhiều nguy cơ. Ví dụ như chiết xuất tế bào gốc từ cùng một loại mô nhưng từ những người khác nhau sẽ gây ra phản ứng dị ứng, tức là hơn Tình trạng đào thải cấy ghép bắt đầu sau nhiều năm điều trị nghiêm trọng hơn. Trong trường hợp lấy tế bào gốc từ cơ thể người và tự sử dụng tế bào gốc, các phản ứng dị ứng có thể xảy ra. Điều này do nguy cơ dị ứng do các thành phần hoặc hợp chất gây ra trong quá trình nuôi cấy. Khi tiêm vào cơ thể Không thể kiểm soát hoàn toàn sự phát triển và biệt hoá của tế bào gốc trong cơ thể dẫn đến xuất hiện các khối u thứ cấp, bác sĩ Tú cho biết kỹ thuật tiêm tế bào gốc thẩm mỹ này không an toàn 100% .—— Lê Phương